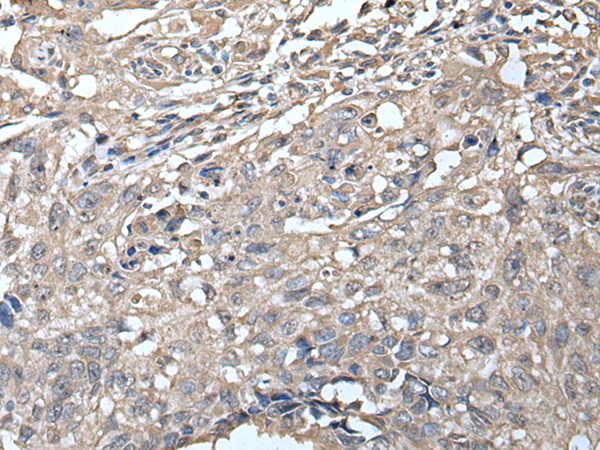

Background:
The protein encoded by this gene belongs to the immunoglobulin superfamily and is expressed selectively at the early stages of B cell development, namely, in proB and early preB cells. This gene encodes the iota polypeptide chain that is associated with the Ig-mu chain to form a molecular complex which is expressed on the surface of pre-B cells. The complex is thought to regulate Ig gene rearrangements in the early steps of B-cell differentiation. Alternative splicing results in multiple transcript variants.
Applications:
ELISA, IHC
Name of antibody:
VPREB1
Immunogen:
Synthetic peptide of human VPREB1
Full name:
pre-B lymphocyte 1
Synonyms:
IGI; IGVPB; VPREB; CD179a
SwissProt:
P12018
ELISA Recommended dilution:
500-1000
IHC positive control:
Human thyroid cancer
IHC Recommend dilution:
20-100
購物車
幫助
021-54845833/15800441009
